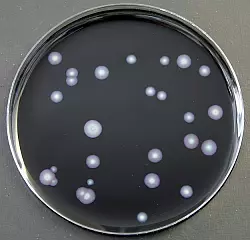
Legionellen-Bakterien.

Herford (NW/me). Im Ludwig-Jahn-Stadion in Herford herrscht Duschverbot: Bei einer Routinekontrolle wurden im Wasserleitungssystem des Stadions Legionellen entdeckt. Die Leitungen werden jetzt von einem Spezialunternehmen vollständig untersucht und chemisch gereinigt.
Legionellen können für den Menschen lebensgefährlich sein, wenn er die Bakterien einatmet. Das Stadion wird ab Mittwoch gesperrt.
Nach Angaben der Stadt Herford ist ein Defekt in der Trennung zwischen Warm- und Kaltwasser die Ursache für die Verunreinigung.
Für Training und Testspiele gibt es Ersatz-Umkleidekabinen und Toiletten. Das Jahn-Stadion soll am Mittwoch in einer Woche wieder voll nutzbar sein.